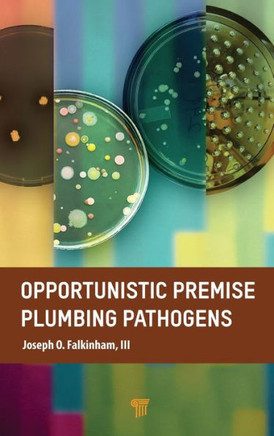
Opportunistic Premise Plumbing Pathogens Opportunistic Premise Plumbing Pathogens

Jenny Stanford Publishing
Opportunistic Premise Plumbing Pathogens
Product Code:
9789814968409
ISBN13:
9789814968409
Condition:
New
$157.89

Opportunistic Premise Plumbing Pathogens
$157.89
This book describes the shared characteristics of the emerging group of water-borne pathogens that are normal inhabitants of drinking water systems and premise plumbing. It discusses the selective conditions of drinking water distribution systems and premise plumbing that have led to the emergence of OPPPs.
| Author: NA |
| Publisher: Jenny Stanford Publishing |
| Publication Date: Mar 31, 2023 |
| Number of Pages: NA pages |
| Language: English |
| Binding: Hardcover |
| ISBN-10: 9814968404 |
| ISBN-13: 9789814968409 |